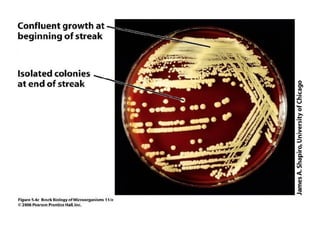

Bacteria require certain environmental conditions to grow and multiply, including temperature, pH, oxygen, water, and nutrients. Bacterial metabolism allows bacteria to obtain energy and synthesize cellular components through catabolic and anabolic processes. The products of bacterial anabolism like toxins, enzymes, antibiotics, and pigments have medical significance related to pathogenicity, treatment of disease, and identification of bacteria.